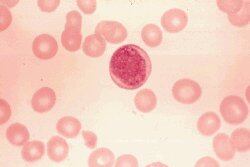

La revista Technology Review , publicada por el Instituto Tecnológico de Massachussets (MIT), seleccionó diez nuevas tecnologías que, según se espera, cambiarán el mundo, tal como lo conocemos.
Los editores de la publicación, como cada año, analizaron el trabajo que se realiza en laboratorios y universidades alrededor del mundo para conformar la lista.
Las tecnologías escogidas se desenvuelven en campos muy diversos y van desde su uso en los hogares hasta la medicina.
Entretenimiento. Uno de los ámbitos que registra mayores avances es el de la recreación.
Según datos de la Universidad de Carnegie Mellon, en Pittsburgh, actualmente la distribución de video en la web consume el 60% del tráfico en Internet, pero se cree que en dos años será el 98% del contenido de los servidores.
Hui Zhang es un científico informático de ese centro de estudios y desarrolla una red P2P (de persona a persona) para el intercambio de videos que ayude a descongestionar la red.
La gran ventaja es la descentralización de los proveedores de Internet, pero preocupa la desprotección de los derechos de autor.
Los teléfonos celulares también experimentarán cambios. Los ingenieros del Centro de Investigación de Nokia, en Finlandia, desarrollan un programa para que, con su teléfono celular, usted logre saber dónde está, pero además sepa qué actividades realizar en dicho lugar, por lo que será mejor que los sistemas satelitales actuales.
Sus creadores afirman que el programa ya está listo y solo falta convencer a las compañías proveedoras de servicio celular de que los usuarios están dispuestos a pagar más por esta herramienta.
La siguiente en la lista es la fotografía. El uso de compresores cambiará la imagen digital como la conocemos hoy. Según Richard Baraniuk y Kevin Kelly, profesores de la Universidad de Rice, en Houston, el sistema actual es ineficiente.
Los investigadores pretenden que, con una nueva fórmula, las cámaras utilicen un único sensor de imágenes que recolecte información para producir unas de alta resolución. Los expertos esperan que, dentro de unos cinco años, los teléfonos celulares sean capaces de captar imágenes del tamaño de un póster y con alta resolución.
Medicina. Los médicos se enfrentan cada día a mayor cantidad de datos de sus pacientes, por lo que a John Guttag, del Departamento de Ingeniería Eléctrica y Ciencias de la Computación del MIT, se le ocurrió que una computadora podría manejar la información y alertarlos sobre alguna enfermedad.
Guttag ha trabajado en la recolección de datos para diagnosticar ataques epilépticos y en el diseño de detectores personalizados. El reto ahora es convencer a los médicos que una computadora es capaz de ayudarlos a tomar decisiones.
La investigación celular también vislumbra cambios. Los científicos han obtenido tradicionalmente las características de las células a partir del estudio de un grupo de ellas.
Sin embargo, Norman Dovichi, un químico de la Universidad de Washington en Seattle, cree que el estudio de las diferencias entre células individuales puede ayudar a mejorar los tratamientos de males como el cáncer y la diabetes.
Ahora imagine si su psiquiatra pudiera tratar su depresión con solo apagar o encender partes de su cerebro. Este es un trabajo que se encuentra en desarrollo por Karl Deisseroth, quien realizó su práctica psiquiátrica en el centro médico de Stanford, en California.
Deisseroth cree que se puede controlar las neuronas por medio de golpes de luz. El experto trabaja en identificar las neuronas responsables de la depresión para desarrollar un medicamento dirigido a las partes relevantes y eliminar los efectos secundarios actuales.
Uno de los avances más innovadores es el uso de pequeñas fibras que podrán salvar a personas durante cirugías o accidentes en el futuro. El científico del MIT, Rutledge Ellis-Behnke, responsable de la investigación, ha hecho pruebas en cirugías con ratas.
Al cortar intencionalmente una artería principal del hígado de uno de estos animales y colocar un líquido transparente en la herida, el sangrado se detiene de inmediato. Este líquido está formado por nanofragmentos de proteína que funcionan como una malla. Según el experto, aún faltan unos diez años para probar su uso en humanos.
Futurista. Otros proyectos parecen, más bien, sacados de una obra de ficción. Tal es el caso de Kenneth Crozier y Federico Capasso, de la Universidad de Harvard, quienes diseñaron antenas ópticas que son alimentadas por la luz y que se espera permitan crear discos similares a los de DVD actuales, pero con una capacidad para almacenar unos 3.6 terabytes, es decir, el equivalente de 750 DVD grabables en un solo disco.
Esta tecnología funciona gracias a que las antenas ópticas son capaces de enfocar el rayo de luz en un punto inferior a los 40 nanómetros, lo cual es equivalente a cerca de un veinteavo de la onda de luz.
Otra apuesta va en el sentido de producir energía solar de bajo costo. Actualmente, los paneles solares para su producción alcanzan precios exorbitantes. La gran novedad es utilizar celdas denominadas “fotovoltaicas” que utilizan semiconductores, como la silicona, para convertir la energía de la luz en corriente eléctrica.
Científicos como Victor Klimov, del Laboratorio Nacional de Los Álamos en Nuevo México, han recurrido a la cuántica, por medio de reacciones químicas, para la producción de energía solar, pero aún les falta crear algún material comerciable.
Por último, en octubre, David R. Smith y un grupo de colegas de la Universidad de Duke, en Carolina del Norte, anunciaron una capa de invisibilidad que trabaja con un conjunto de diez anillos concéntricos, los cuales están hechos de fibra de vidrio cubierto por elementos de cobre.
Aunque los objetos no desaparecen a los ojos humanos, la idea es perfeccionar esta técnica para algún día lograr la invisibilidad. En el experimento de Smith, se colocó un cilindro de cobre en el espectro de microondas y estas no lo reconocieron, por lo que pasaron a través de él.